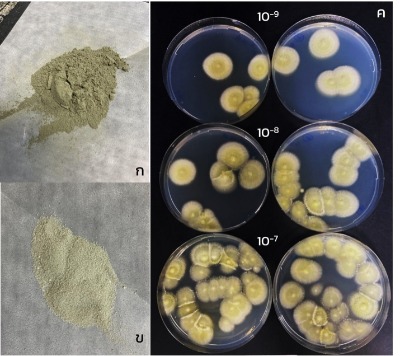

![]() |
สำนักงานจัดการสิทธิเทคโนโลยี Technology Licensing Office |
![]() |

| นักวิจัย นางสาวรัศมี หวะสุวรรณ นายอลงกรณ์ อำนวยกาญจนสิน |
|
| หน่วยงาน ศูนย์พันธุวิศวกรรมและเทคโนโลยีชีวภาพแห่งชาติ สำนักงานพัฒนาวิทยาศาสตร์และเทคโนโลยีแห่งชาติ |
|
| รูปแบบความร่วมมือที่เสนอ เสาะหาผู้รับอนุญาตใช้สิทธิ |
|
| สถานภาพทรัพย์สินทางปัญญา • คำขออนุสิทธิบัตร เลขที่คำขอ 2403002833 ยื่นคำขอวันที่ 3 กันยายน 2567 • ความลับทางการค้า |
|
| สถานะงานวิจัย ต้นแบบระดับห้องปฏิบัติการได้ถูกทดสอบในสภาวะจำลอง (TRL5) |
| ที่มา ข้อมูลเบื้องต้น ความสำคัญของปัญหา สูตรชีวภัณฑ์ราเมตาไรเซียมรูปแบบเดิมใช้วัสดุรองรับที่เป็นดินขาวไม่ละลายน้ำ พบปัญหาการตกตะกอนและอุดตันหัวฉีดพ่น ไม่สามารถนำมาใช้กับระบบน้ำหยดหรือสปริงเกลอร์ได้ อีกทั้งพบปัญหาการทิ้งคราบบนใบพืชหรือผลผลิต และเมื่อเก็บรักษาที่อุณหภูมิสูง 35 องศาเซลเซียส นานกว่า 16 สัปดาห์ พบปัญหาการเสื่อมคุณภาพโดยพบจำนวนสปอร์ต่ำกว่ามาตรฐานที่กรมวิชาการเกษตรกำหนดคือ 1 x 108 ซีเอฟยู/กรัม ส่งผลให้ประสิทธิภาพการเข้าทำลายแมลงลดลงเช่นกัน ทีมวิจัยจึงพัฒนาชีวภัณฑ์ราเมตาไรเซียมที่ละลายน้ำเพื่อจัดการแมลงศัตรูพืชนี้จะช่วยแก้ปัญหาดังกล่าว โดยชีวภัณฑ์สามารถละลายน้ำได้ง่ายรวมถึงช่วยยืดอายุการเก็บรักษาที่อุณหภูมิสูงได้ยาวนานกว่าเมื่อเทียบกับชีวภัณฑ์ราเมตาไรเซียมที่มีมาก่อน |
| สรุปเทคโนโลยี 1.สูตรชีวภัณฑ์ในรูปแบบผงที่ละลายน้ำได้ดี เป็นอีกทางเลือกที่ช่วยเพิ่มความสะดวกในการใช้ชีวภัณฑ์ให้กับเกษตรกร ลดปัญหาการอุดตันหัวฉีดพ่นและคราบตกค้างบนพืชและผลผลิต รวมถึงการนำไปใช้กับระบบน้ำหยดหรือสปริงเกลอร์ ลดปัญหาการขาดแคลนแรงงานและลดต้นทุนแรงงาน 2. เก็บรักษาที่อุณหภูมิสูง 40 องศาเซลเซียส (คงที่) ได้นานกว่า 5 เดือนครึ่ง (22 สัปดาห์) โดยคงคุณภาพของสปอร์เทียบเท่าการเก็บรักษาที่อุณหภูมิ 25-30 องศาเซลเซียส เป็นเวลามากกว่า 1 ปี 3. คงประสิทธิภาพในการทำลายแมลงได้ไม่ต่ำกว่าร้อยละ 70 แม้เก็บที่อุณหภูมิสูง 40 องศาเซลเซียส คงที่ นานกว่า 8 สัปดาห์ |
| สนใจสอบถามข้อมูล ตัวแทนอนุญาตใช้สิทธิ งานธุรกิจทรัพย์สินทางปัญญา สำนักงานจัดการสิทธิเทคโนโลยี (TLO) โทรศัพท์: 025647000 ต่อ 1357 E-mail: tlo-ipb@nstda.or.th |